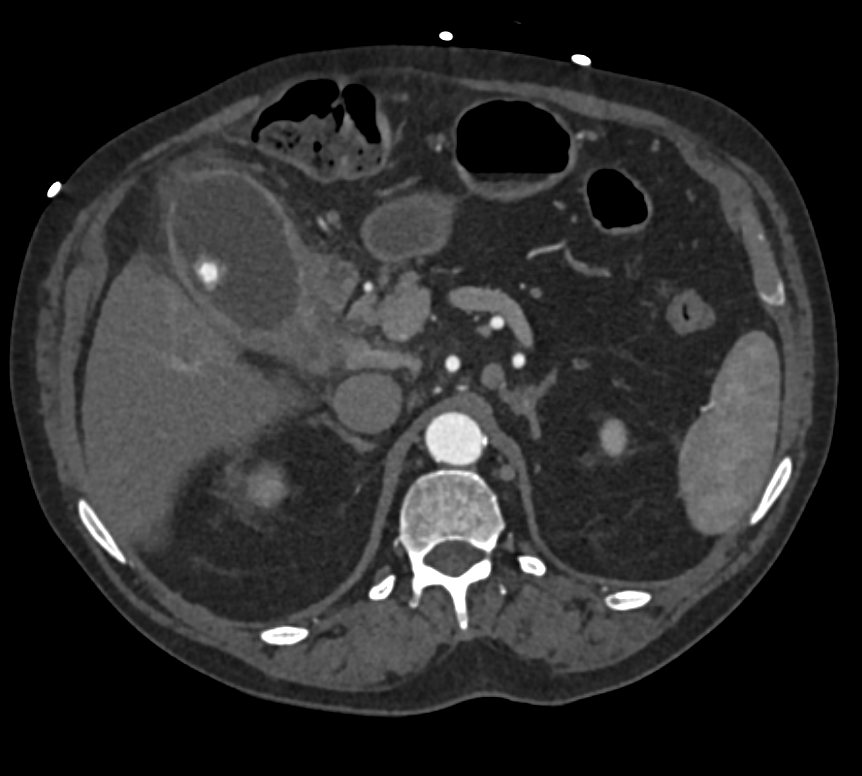
Elliot K Fishman / CTisus.com tweet media
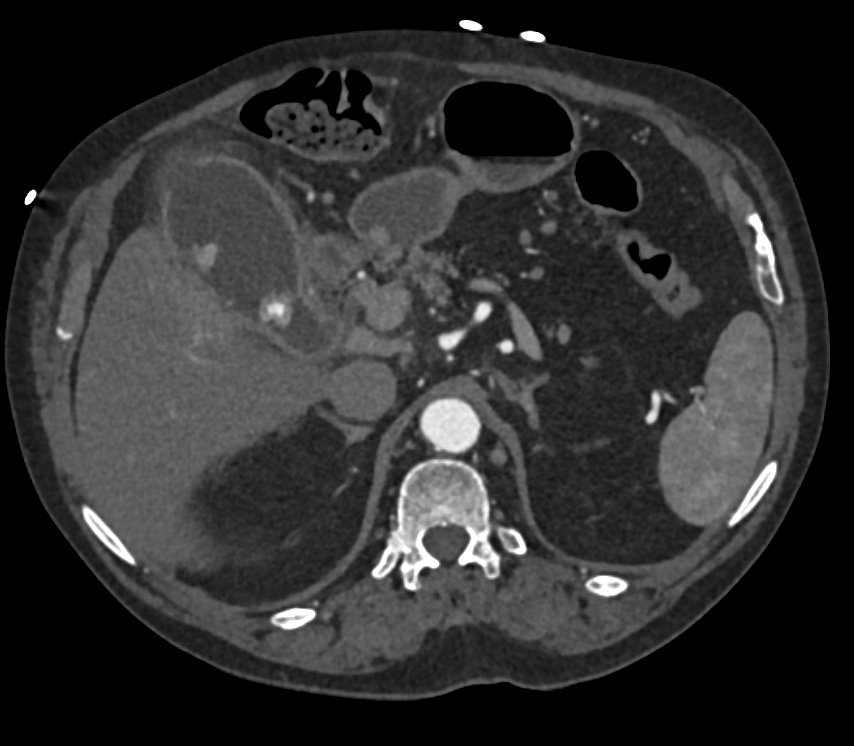
Elliot K Fishman / CTisus.com tweet media
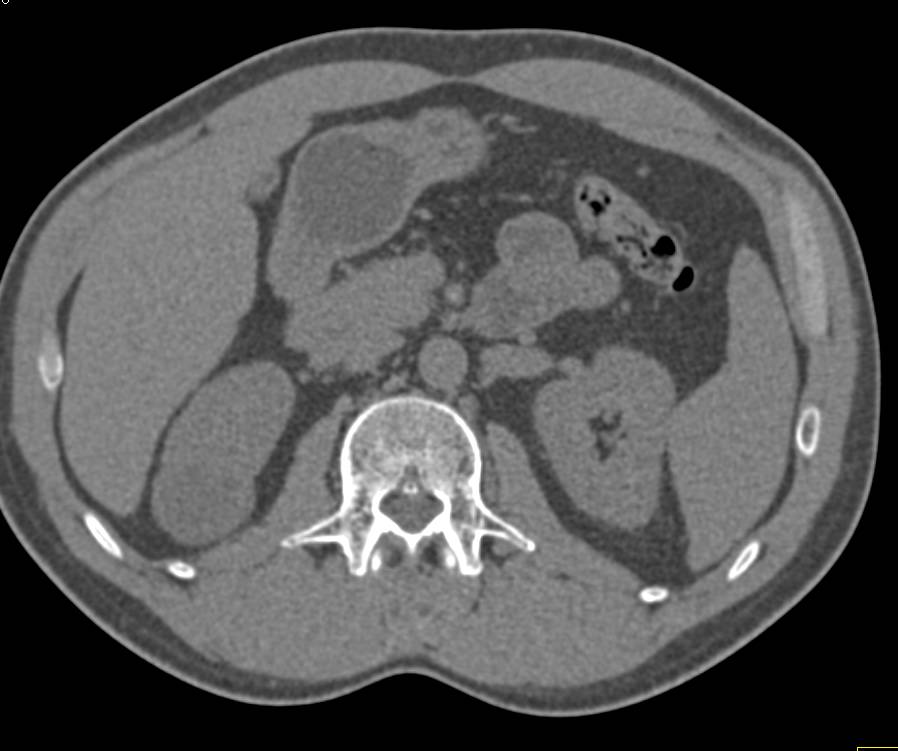
Elliot K Fishman / CTisus.com tweet media
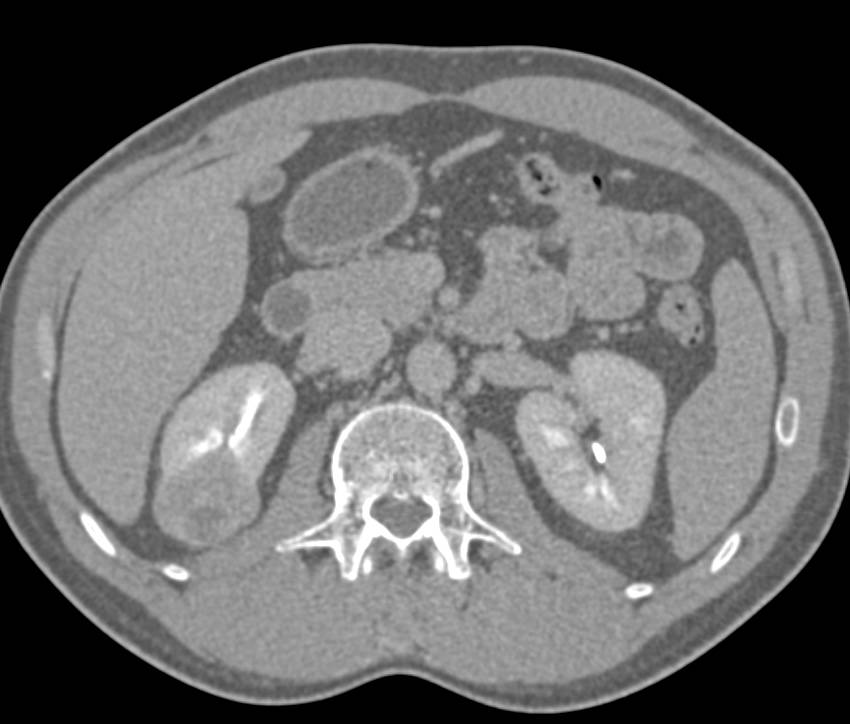
Elliot K Fishman / CTisus.com tweet media

Sabitlenmiş Tweet

This past week, Threads surpassed X in daily active users. It's not surprising considering our engagement has been much lower than it used to be.
Remember that we're also on multiple other social media platforms and, as always, the best way to keep in touch is via our newsletter: ctisus.com/about/newslett…

English